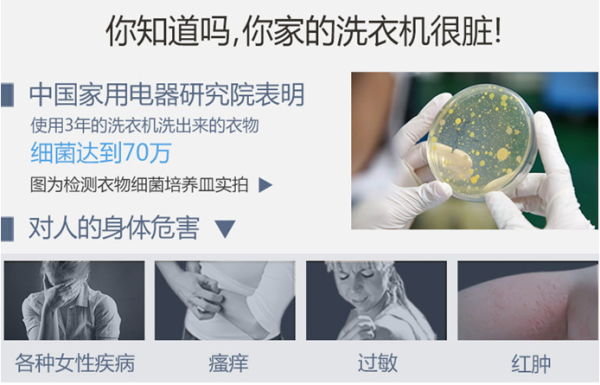
2

4月26日在TCL空调+新品发布会上,TCL免污式洗衣机系列产品再次集体亮相,引发行业和用户的高度关注。作为行业全免污系统解决方案的创立者,TCL冰箱洗衣机专注用户需求,精耕细分市场,传递着健康真好生活的理念。

健康洗衣成为消费新需求 告别洗衣二次污染危害刻不容缓
洗衣机承担着家庭的清洁重任,从过去的洗衣服,到如今洗出干净的衣服,消费者的这一需求变化,体现的是对健康的需求,对生活品质的追求。拥有一台能够彻底洗净衣物,同时能够节水、节电的洗衣机成为用户需求。
传统洗衣机完全不能洗干净衣物。中国家电研究院在调查中发现,使用3年的传统洗衣机洗出来的衣物,细菌含量可达70万。2016中国家用电器会议德国VDE的研究报告也表明,洗衣机内藏有大量污垢残留,这会产生大量细菌,最终形成细菌粘膜,导致洗涤的衣服产生异味或者黑色斑点,被二次污染。
洗衣二次污染主要包括两种,一种洗衣机对衣物的二次污染,另一种是衣物与衣物之间的交叉污染。衣物与衣物之间的交叉污染常常被忽视,而事实上,衣物混洗引发的交叉污染同样可怕!通常情况下,我们穿过的衣物会有多种细菌,如果不将内外衣、大人与小孩的衣物加以区分,不管是混合存放还是混合洗涤,都会造成交叉污染,引发妇科炎症久治不愈、儿童感染妇科病、皮肤敏感反复发作以及免疫力低下等问题,时刻威胁家人健康。

传统解决方式 治标不治本
洗衣机行业现有的解决洗衣二次污染的方法多半是采用外力清洁的方法。比如针对波轮洗衣机,采用“筒自洁+筒风干”自清洁功能,或使用清洁剂、消毒液清洗,或增加“清洁球”摩擦清洗;对于滚筒洗衣机,采用高温除菌、高速水冲刷、或清洗剂等机洗剂去污,这些方法都是有了污染后才被动清理,从空间上说只能少部分除污或杀菌(仅限高温),最好的除污效果不超过30%,在时间上不能实时除污或杀菌(仅限高温),仅停留浅层的物理或化学去污,污染永远存在,没有真正彻底解决洗衣二次污染难题。按治病来说属于“头疼医头,脚疼医脚”,没找到病根治不了病,治标不治本!
而对于衣物对衣物的交叉污染,目前市面上也提出了一些解决方案,比如上下双层洗衣机,但这种洗衣机本身就存在着洗衣机二次污染的问题,同时整机成本偏高,振动大,稳定性差,收集、晾晒衣服都不方便;也有分区清洗洗衣机,这种洗衣机同样没有解决洗衣机对衣物的污染,只是将衣物简单区分洗涤,没有在收集和存放环节解决衣物与衣物之间的交叉污染,而且体积较大,对用户的居住空间有一定的要求。
当前很多家庭已经意识到了衣物与衣物之间的交叉污染,所采取的措施多半为小孩的衣物进行手洗,贴身内衣小物手洗,但这种洗涤方式非常浪费时间和体力。更重要的是,对于衣物与衣物的交叉污染问题,手洗仅仅只能解决洗涤过程中的交叉污染,并不能解决收集和存放中的交叉污染。
首创免污式桶中桶洗衣机 大桶免污小桶免污专属 为家人健康定制专属洗涤空间
针对困扰行业多年的洗衣二次污染难题,TCL推出免污式桶中桶洗衣机,创新采用1+N的方案——1指的是外部的免污式大桶,N指的是内部的专属免污小桶。其中,外部大桶采用全新专利的全封桶结构、可清洗分体式全钢波轮和一体式全钢内筒底,解决洗衣机本身藏污纳垢对衣物的二次污染问题。小桶为全封闭免污专属桶,与大桶水流完全隔离,采用流量计进水阀,精确计算,水位自动控制,解决了衣物与衣物在洗涤过程中的交叉污染问题。

“N”的设计尤其凸显了对用户需求的洞察,实现一台洗衣机解决全家人专属洗涤的需求。多种不同专属洗涤小桶设计,专属桶采用可分离设计,即装即洗,提桶晾晒,安装仅需5秒,洗完即时取出,可以随时取放,实现一台洗衣机,解决全家人专属洗涤需求,1+N种组合,创造无限专属洗涤,每个家庭成员都可以选择自己的专属小桶,用来收集、洗涤和储存自己的衣物,与其他人的衣物彻底分开。不仅如此,独有的手搓式洗涤设计,为贴身内衣、儿童衣物提供专属的洗涤呵护,真正做到解放双手,成为洗衣的好帮手。

TCL免污式桶中桶洗衣机的外部大桶采用的是免污式洗衣机的全封桶结构,单次洗涤可节水30%以上,专属免污小桶单次洗涤节水超过80%。外观也延续使用了免污式洗衣机的设计,此设计曾获得2016德国iF设计大奖。这款内外兼修的TCL免污式洗衣机,在近期热播的《黄小厨的春夏秋冬》第四季节目中也被黄小厨特别推荐。

如此给力的洗衣机,成为生活品质的必备之选,TCL冰箱洗衣机也在4月28-日5月7日期间,贴心推出超级优惠,在全国范围内强势开启真免污、好风冷“5重好礼,1促即发”新品推广活动,不仅免污式洗衣机让健康回家,TCL一体变频风冷冰箱等明星产品也在福利之列,TCL冰箱洗衣机黄小厨五一‘价’到,速来约‘惠’,等你来约!



